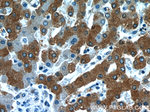
RELN Antibody in Immunohistochemistry (Paraffin) (IHC (P))

Search
Proteintech
RELN Polyclonal Antibody
{{$productOrderCtrl.translations['antibody.pdp.commerceCard.promotion.promotions']}}
{{$productOrderCtrl.translations['antibody.pdp.commerceCard.promotion.viewpromo']}}
{{$productOrderCtrl.translations['antibody.pdp.commerceCard.promotion.promocode']}}: {{promo.promoCode}} {{promo.promoTitle}} {{promo.promoDescription}}. {{$productOrderCtrl.translations['antibody.pdp.commerceCard.promotion.learnmore']}}
图: 1 / 6
RELN Antibody (20689-1-AP) in IHC (P)

产品信息
20689-1-AP
种属反应
宿主/亚型
分类
类型
抗原
偶联物
形式
浓度
规格
纯化类型
保存液
内含物
保存条件
运输条件
靶标信息
Reelin in an extracellular matrix serine protease that plays a role in layering of neurons in the cerebral cortex and cerebellum. Regulates microtubule function in neurons and neuronal migration. Affects migration of sympathetic preganglionic neurons in the spinal cord, where it seems to act as a barrier to neuronal migration. Enzymatic activity is important for the modulation of cell adhesion. Binding to the extracellular domains of lipoprotein receptors VLDLR and LRP8/APOER2 induces tyrosine phosphorylation of DAB1 and modulation of TAU phosphorylation.
仅用于科研。不用于诊断过程。未经明确授权不得转售。
篇参考文献 (0)
生物信息学
蛋白别名: extracellular matrix serine protease; Reeler protein; Reelin; unnamed protein product
基因别名: ETL7; LIS2; PRO1598; reeler; RELN; RL
UniProt ID: (Human) P78509, (Mouse) Q60841
Entrez Gene ID: (Human) 5649, (Mouse) 19699



